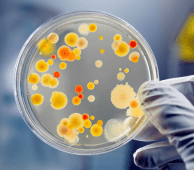
Petri Dish

Readers: this blog is set in the future (sometime after the year 2020). Each entry assumes there has been a 5th revolution in the US — the Revenge Revolution. More about the Revenge Revolution, a list of earlier revolutions and the author, Entry #1.
Periodically I write a “sense check” to assess whether in the next few years, a revolution in the US is still possible or whether the entire exercise is based on a statistical aberration — i.e., a roughly 50-year cycle between major upheavals in the US. Most recent sense check, Entry #365.
Some of the entries are part of a series. Several series are available as easy-to-read booklets for download:
- Working with Lee Iacocca after he left Chrysler, 2019Q3 Iacocca Personal Observations.
- GM EV1 — behind-the-scenes events affecting development and introduction of the GM EV1, the first modern electric vehicle. 2020Q1 GM EV-1 Story Behind the Story Booklet
- Coming technology tsunami and the implications for the US, Tech Tsunami Booklet with Supplement
- Trump Supporters Brainwashed? A series discussing why Republics have abandoned basic principals, Are Trump Republicans Brainwashed 2020Q1
- Who took out the Donald? Who/what groups are most likely to “take out” Trump? Who Took Out the Donald Entries with Update
- Revenge Revolution — description of what form the revolution might take, 20 01 07 Start of Revolution
Prelude: there is an endless number of inconsistencies in information from the Trump administration about the spread of the coronavirus and/or actions to mitigate the spread. For this blog entry we take a look at trying to understand why Trump behaves the way he does. What’s really behind his behavior?
ENTRY #377 BEGINS: Last week I ended the entry expressing hope that the experience and sacrifices associated with the coronavirus would help bring the US populace closer together. Being closer, in turn, would reduce the severity of the likely Revenge Revolution. Behavior by most of the public this past week seems to reinforce that hope.
What is far less clear is understanding the behavior and decisions by Trump. You have to ask yourself, “Why such behavior?” It makes no sense.
My training in undergrad and grad school and most jobs in my professional career have been to analyze data and then forecast events/outcomes. The challenge with forecasting is to articulate reasonable, actionable actions before the situation becomes obvious and more difficult to control. In addition, recommended actions that provide the most lead time often are necessarily, but also may be based on seemingly disparate data points.
Those who make predictions understand their forecasts are almost always wrong. Naysayers and “Monday-morning quarterbacks” love to nitpick and point out errors in the predictions. However, those who make decisions based on predictions understand that a good, actionable prediction doesn’t have to be 100% correct. A good prediction only needs to presents reasonably accurate outcomes for the most relevant variables before the situation becomes obvious and actions to control the situation less effective.
With that background, let’s turn to the behavior of Donald Trump as president. From my perspective there is something or maybe a set of variables driving his behavior that is not obvious. If one steps back and analyzes the possible consequences of the behavior, the likely outcomes of Trump’s actions seem contrary to the best interests of the United States. So, why such behavior?
Yes, Trump’s narcissistic. Yes, Trump’s crude, rude and a bully. Yes, he’s under educated and lazy. And, yes, he’s a wannabe Mafia Don. But none of those traits explains his decisions in certain key situations and his relationship with certain people.
Following is top-of-mind list of behavior and/or decisions that to me are inexplicable. With a bit of work, the list would be at least five times as long. Here’s the very short list:
- Post-inaugural closed-door meeting in the White House with the Russian ambassador, a known spy. After the meeting the transcript was destroyed. Why?
- Public and intense alienation of NATO allies while publicly courting Putin. Why?
- Refusing to release tax returns. Then, when ordered to provide tax returns to a Congressional committee, which is written in the tax code, refuses to do so and takes case to court. Why?
- When signing the $2 trillion coronavirus stimulus, adding an “executive exclusion” that claims the House of Representatives does not have the right of oversight for the expenditures and that he, Trump, will provide oversight. Why?
- Overruling vigorous protests by the FBI and CIA and issuing son-in-law Jared Kushner a top secret clearance. The agencies indicated Kushner’s behavior and associations disqualified him from such a clearance. What about the son-in-law’s behavior is so shady?
- Praising Navy SEAL Gallagher and then awarding him the Presidential Medal of Freedom when there was overwhelming evidence of criminal wrongdoing. Why go against the recommendations of the military?
- Trash-talking Navy Captain Brett Crozier of the aircraft carrier Theodore Roosevelt for trying to protect his crew from the coronavirus. Unlike Gallagher, Captain Crozier was praised as a hero by officers and enlisted sailors. Why praise Gallagher and trash-talk Crozier?
- Appointing cabinet officials with clear conflicts of interests, starting with General Flynn and his interactions with Russia and Turkey. Trump was informed of Flynn’s conflicts before the appointment, yet went ahead. Most of the Cabinet appointees have little or no experience in the department. In addition, Trump has consistently appointed “acting” staff members, apparently to avoid having the person be subjected to review by the Senate. Why?
- Claiming that he (Trump) had influenced the Saudis and the Russians to agree to raise oil prices. Just a few days before claiming he helped raise oil prices, Trump claimed that lower oil prices were like a tax cut for consumers. Whatever Trump offered the Saudis and the Russians didn’t work since the “deal” has been delayed. What was in this for Trump?
- Refusal to have the federal government take the lead in coordinating a response to the coronavirus. Only after extreme pressure did Trump invoke the Defense Production Act, which forced companies to make certain products and then sell the products to the Federal government at a certain price. But rather than the Federal government taking possession, Trump directs the companies to ship the products to private distributors, who are allowed to resell the products to the various states, often at 10x the price paid by the Federal government. Why?
There are many other examples, including the behavior of Attorney General Barr. But in each case one must ask, why? If any of these actions were part of a presidential campaign platform, would Trump have been elected? Obviously not. Who would vote for a candidate, for example, who says, “I’m going to insult NATO allies, and especially insult the English, French and Germans. Then I’m going to cozy up to a known enemy of the United States, the Russians.”
Here’s my take on Trump’s behavior and no one should be surprised. The Russians, for sure, likely the Saudis, and maybe the Chinese have Trump by the short hairs. Why? Because of backroom unreported financial deals, which likely involve laundering money. Recall, the only bank that would lend Trump money after his series of bankruptcies and defaulting on payments was Deutsche Bank. Which bank has been indicted and fined for laundering money? (Guess Deutsche Bank.) Who did Trump appoint as Commerce Secretary? None other than Wilbur Ross, the former chairman of Cyprus Bank, a bank notorious for laundering money.
Don’t be fooled by Trump’s bluster and claim that he’s tough on the Russians and Chinese. Look behind the curtain and see the sanctions against the Russians are a farce. The tariffs against Chinese goods are more show than substance. Think about this. Could the tariffs have been part of a deal where Trump agreed to walk away from the Trans-Pacific Partnership? The agreement would have strengthened America’s influence in Asia. By walking away, did Trump let the Chinese begin to dominate trade in Southeast Asia in exchange for some payment to Trump?
Even without his tax returns, there’s enough evidence to indicate Trump is up to his eyeballs in debt. Trump, Jr even bragged at the private club Trump bought north of Charlotte that the Russians were the source of money for many Trump projects. There’s enough evidence to suggest the Saudis have also provided cash to Trump.
Before the coronavirus, cash flow at many Trump properties was declining, and in some cases, cash flow was negative. The drop-off in cash flow associated with the Coronavirus has made the situation much worse. On April 4, the Trump Organization announced layoffs of 1,500 people. And more layoffs are likely to come.
Let’s pause for now and just ask ourselves, why in Trumpland does everything seem backwards? Why in Trumpland does black look like white? Why in Trumpland does down look like up? Why is irrational considered rational? And endless other dichotomies.
Over the next week, step back and view Trump’s remarks in the context of the questions raised and why everything seems backwards. Stepping back might provide some interesting insight, or at least raise more questions. To be continued.

 Greenie: “Now, Jordan. Yes, it’s nice to see you but when did you need protection? Has JC been harassing poor little Jordie?”
Greenie: “Now, Jordan. Yes, it’s nice to see you but when did you need protection? Has JC been harassing poor little Jordie?” JC: “You want something far out…no pun intended.”
JC: “You want something far out…no pun intended.” Jordan: “Greenie, maybe Ms. Einstein is on to something. I’ve never really bought into the Big Bang Theory. Understand the theory but what I can’t figure out is where did the matter come from?”
Jordan: “Greenie, maybe Ms. Einstein is on to something. I’ve never really bought into the Big Bang Theory. Understand the theory but what I can’t figure out is where did the matter come from?” Jordan: “Green is not my color. I like ET’s friends better. Seriously…if that’s possible with this group…I’ve always been fascinated by the number of stars. Now after the Hubble telescope, we know there are even more billions of stars and millions, if not billions of galaxies.”
Jordan: “Green is not my color. I like ET’s friends better. Seriously…if that’s possible with this group…I’ve always been fascinated by the number of stars. Now after the Hubble telescope, we know there are even more billions of stars and millions, if not billions of galaxies.” Jordan: “We know…let me rephrase that…there appear to be more than three dimensions. We don’t know exactly how many but let’s say there are five dimensions.”
Jordan: “We know…let me rephrase that…there appear to be more than three dimensions. We don’t know exactly how many but let’s say there are five dimensions.” Greenie: “One of ET’s buddies has this experiment. And as part of that experiment there is a giant petri dish called earth. ET’s buddy puts of few drops of something in the dish and things start to grow.”
Greenie: “One of ET’s buddies has this experiment. And as part of that experiment there is a giant petri dish called earth. ET’s buddy puts of few drops of something in the dish and things start to grow.” Jordan: “Does it really matter who believes it? Probably not. However, more people might be closer to believing it than we think. I find it very interesting that when you look at the core beliefs of a bunch of different religions, there always seems to be some ‘super-power’ of sorts at the top.”
Jordan: “Does it really matter who believes it? Probably not. However, more people might be closer to believing it than we think. I find it very interesting that when you look at the core beliefs of a bunch of different religions, there always seems to be some ‘super-power’ of sorts at the top.” Jordan: “Never admitting a mistake was really his downfall.”
Jordan: “Never admitting a mistake was really his downfall.” Jordan: “What a great way to start a presidency. Go to confession and beg for forgiveness.”
Jordan: “What a great way to start a presidency. Go to confession and beg for forgiveness.” Jordan: “I know what you’re saying. Since Trump did the country such a favor, maybe we should put his face on Mount Rushmore.”
Jordan: “I know what you’re saying. Since Trump did the country such a favor, maybe we should put his face on Mount Rushmore.” Matt: “First of all, if Trump really cared about these kids…actually many were young adults…he could have let Obama’s Executive Order continue or issued another one. What was so pressing?”
Matt: “First of all, if Trump really cared about these kids…actually many were young adults…he could have let Obama’s Executive Order continue or issued another one. What was so pressing?” Matt: “Trump’s rationale wasn’t really about whether these children had legal standing. Trump’s argument was ‘those illegals’ were stealing jobs that Trump claimed rightfully belonged to Trump supporters. In reality the DACA kids were creating jobs and likely qualified for higher-tech jobs…jobs that many Trump supporters weren’t qualified for.”
Matt: “Trump’s rationale wasn’t really about whether these children had legal standing. Trump’s argument was ‘those illegals’ were stealing jobs that Trump claimed rightfully belonged to Trump supporters. In reality the DACA kids were creating jobs and likely qualified for higher-tech jobs…jobs that many Trump supporters weren’t qualified for.” Matt: “The DACA Detour, as I call it, was an effort to steer away from the every widening Russia investigation. Many in the public realized the terrible precedent that DACA set. DACA finally got evangelicals off their butt and they started saying no to Trump.”
Matt: “The DACA Detour, as I call it, was an effort to steer away from the every widening Russia investigation. Many in the public realized the terrible precedent that DACA set. DACA finally got evangelicals off their butt and they started saying no to Trump.” Jordan: “The question is what did the deal accomplish? The Republicans would have passed legislation for the debt ceiling to keep the government operating, even if it took having Democrats join them. But Trump’s ego needed a fix, like right now, so he gave McConnell and Ryan the finger on camera and proceeded to play footsie with Pelosi.”
Jordan: “The question is what did the deal accomplish? The Republicans would have passed legislation for the debt ceiling to keep the government operating, even if it took having Democrats join them. But Trump’s ego needed a fix, like right now, so he gave McConnell and Ryan the finger on camera and proceeded to play footsie with Pelosi.” alienating virtually everyone in Congress and much of the public.”
alienating virtually everyone in Congress and much of the public.”













